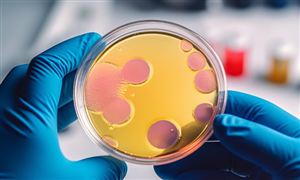
2024年海运产业发展现状及重点企业经营情况(图3)

海洋运输,也被称为国际海洋运输,是国际物流中最为关键的运输方式。它利用船舶在海上航道上将货物从一个国家的港口运送到另一个国家的港口,广泛应用于国际货物运输。海洋运输在全球贸易中占据了极为重要的地位,国际贸易总运量中有2/3以上都依赖于海洋运输,而中国进
海洋运输,也被称为国际海洋运输,是国际物流中最为关键的运输方式。它利用船舶在海上航道上将货物从一个国家的港口运送到另一个国家的港口,广泛应用于国际货物运输。海洋运输在全球贸易中占据了极为重要的地位,国际贸易总运量中有2/3以上都依赖于海洋运输,而中国进出口货运总量的约90%都是通过海洋运输完成的。
随着全球制造业的不断聚集和中国物流需求的日益增长,海洋运输的重要性愈发凸显。为了应对这一挑战,我国提出了到2035年基本建成现代化高质量国家综合立体交通网的目标。为了实现这一目标,国家出台了一系列发展政策和发展规划,以促进海运行业的健康发展。
各省市积极响应国家号召,推动海运行业的发展。例如,上海市发布了《上海市推进多式联运发展优化调整运输结构实施方案》,深化“互联网+”应用,推动铁路、港口、机场、海运、空运等部门企业信息系统对接和数据共享。此外,还加快推进北斗系统在营运车船上的应用,以实现运输全程的可监测、可追溯。
海洋运输在全球经济中发挥着不可或缺的作用,对于国际物流和国际贸易具有重要意义。在未来,随着技术的进步和基础设施的完善,海洋运输将继续发挥其优势,为全球经济的繁荣和发展做出更大的贡献。
根据中研普华产业研究院发布的《2024-2029年海运产业现状及未来发展趋势分析报告》分析
海运业作为全球经济的重要支柱,其上游产业主要包括造(修)船和港口码头等基础设施供应产业,这些产业为海运业提供必要的设备和设施。而下游服务领域则涉及钢铁、房地产等国民经济基础行业,这些行业的发展状况对海运业的需求有着直接影响。
海运业根据运输货物的不同,主要划分为干散货运输、油品运输和集装箱运输等。这些细分市场的发展趋势和需求变化,对整个海运业的发展具有重要影响。整条产业链的传导作用自下而上,即下游的运输需求会拉动海运的繁荣兴衰。
然而,上游造船业供应的较长周期,可能会加大行业供需错配的矛盾,引起周期的较为剧烈波动。为了应对这种波动,越来越多的企业开始采用远期运费协议(FFA)等衍生工具来进行套期保值,这使得海运业与金融业的联系越来越紧密。
海运业的发展状况与上下游产业的发展密切相关,同时也受到金融市场的影响。为了应对市场变化和风险,企业需要密切关注市场动态,加强风险管理,并积极寻求创新发展。

根据海关统计数据,2022年我国外贸进出口总值达到了42.07万亿元,比2021年增长了7.7%。其中,出口总额为23.97万亿元,增长了10.5%;进口总额为18.1万亿元,增长了4.3%。这些数据显示出我国外贸持续增长的态势。
在结构方面,我国外贸持续优化。2022年,一般贸易进出口总额为26.81万亿元,比2021年增长了11.5%。这表明我国在一般贸易领域的发展势头强劲。
在贸易伙伴方面,东盟继续保持我国第一大贸易伙伴的地位,占我国外贸总值的15.5%。同时,我国与“一带一路”沿线国家的进出口合计达到了13.83万亿元,比2021年增长了19.4%。这表明我国与“一带一路”沿线国家的贸易合作不断深化。
此外,我国与RCEP其他14个成员国的合计进出口总额为12.95万亿元,比2021年增长了7.5%。这表明RCEP协议的实施对我国与这些国家的贸易关系产生了积极影响。
在水上货物运输方面,2022年全国港口完成货物吞吐量达到了156.85亿吨,其中外贸货物吞吐量为46.07亿吨;完成集装箱吞吐量达到了2.96亿TEU。水上货物运输业是全球贸易的重要支柱,由于全球资源分布不均衡和经济发展水平不平衡,国际间的贸易需求大量存在。相比其他运输方式,水上货物运输具有成本低、运量大和运距长的优势,全球90%以上的贸易量是通过水上运输完成的。
据克拉克森统计数据显示,2022年全球海运贸易量达到了120亿吨。其中,全球海运煤炭贸易总装运量为12.049亿吨,比上年同期增长了5.9%;全球原油海运量达到19.2亿吨,分别较 2020 年和 2021 年上涨 4.0%和 8.3%,但仍未回到 2019 年的水平。
随着我国贸易量的持续扩大,水上货物运输业也得到了迅速发展。自2012年至2022年,我国水路货运量由45.87亿吨上升至85.54亿吨,年均复合增长率达到6.43%。沿海、远洋及内河运输货运量均呈现逐年上升的趋势。即使在新冠肺炎疫情的影响下,我国经济实现较快复苏,水路货运量在2021-2022年仍保持递增趋势。
中国远洋海运集团有限公司。作为世界领先的综合性海洋运输服务提供商,中国远洋海运集团在全球航运业中具有重要影响。公司业务涵盖了集装箱、干散货、油气运输以及物流和航运金融等多个领域,为全球客户提供一站式服务。近年来,公司通过收购兼并和战略合作等方式不断扩大业务规模,进一步提高全球市场份额。
招商局集团是中国历史最悠久的海运企业之一,业务范围涵盖了航运、港口、物流等领域。公司在国内外拥有多个港口和码头,并拥有多支现代化船队。近年来,招商局集团积极拓展新兴市场,并在数字化和绿色化方面加大投入,以适应行业发展趋势。
山东海运股份有限公司是山东省属国有大型海运企业,拥有完善的海运网络和先进的船舶装备。公司主要从事国际货运代理、船舶代理、船舶租赁等业务,并拥有多个自营船队。近年来,山东海运股份有限公司积极拓展多元化业务,包括海洋旅游、海洋牧场等新兴领域。
厦门象屿集团有限公司是一家以物流和供应链管理为主业的企业,拥有多个物流园区和港口码头。公司通过引进先进的信息技术和智能化装备,提高了物流效率和供应链管理能力。同时,公司还积极拓展海外市场,为全球客户提供更加全面的服务。
以上是中国海运产业部分重点企业的经营情况。这些企业在国内外市场上拥有较高的知名度和影响力,其经营情况对于了解整个海运产业的现状和发展趋势具有一定的参考价值。
了解更多本行业研究分析详见中研普华产业研究院《2024-2029年海运产业现状及未来发展趋势分析报告》。同时, 中研普华产业研究院还提供产业大数据、产业研究报告、产业规划、园区规划、产业招商、产业图谱、智慧招商系统、IPO募投可研、IPO业务与技术撰写、IPO工作底稿咨询等解决方案。

海运研究报告对海运行业研究的内容和方法进行全面的阐述和论证,对研究过程中所获取的海运资料进行全面系统的整理和分析,通过图表、统计结果及文献资料,或以纵向的发展过程,或横向类别分析提...
微生物学服务是提供微生物学相关服务的行业,主要包括微生物检测、微生物培养、微生物鉴定、微生物药敏试验等方面。该...

全球范围技术竞争日趋激烈,科技创新成为重塑国际格局的关键力量。《2022年国民经济和社会发展统计公报》显示:我国全...

贴膏剂是指将原料药物与适宜的基质制成膏状物、涂布于背衬材料上供皮肤贴敷、可产生全身性或局部作用的一种薄片状制剂...

搪瓷,又称珐琅,是将无机玻璃质材料通过熔融凝于基体金属上并与金属牢固结合在一起的一种复合材料。古人们最早使用的...

随着电力和电子工业的发展,电工钢的产能持续增长。新的生产线不断投产,使得电工钢的产量逐年增加,但同时也面临着环...

以“史上最长8天春节假期”为契机,王老吉于2月2日正式推出“超吉星期八”活动。在活动启动仪式上,王老吉发布“超吉2...

中国高锰酸钾行业发展现状及未来发展前景深度分析:高锰酸钾发展前景受到多个因素的影响
【版权及免责声明】凡注明转载来源的作品,均转载自其它媒体,转载目的在于传递更多的信息,并不代表本网赞同其观点和对其真实性负责。中研网倡导尊重与保护知识产权,如发现本站文章存在内容、版权或其它问题,烦请联系。联系方式:、,我们将及时沟通与处理。
多家车企自建远洋船队 比亚迪将有8艘滚装船投入运营 海运产业发展现状及市场竞争格局分析
1汽车巨头宣布 暂停生产 全球供应链受冲击 海运产业发展现状及市场竞争格局分析报告
2中国车企为何纷纷买船出海 不断开拓国际新兴市场 海运产业现状及未来发展趋势分析报告
3航运价格暴涨近600% 全球航运市场发生了什么 海运产业发展现状及市场竞争格局分析报告
42024海运行业现状:国际航运价格飙升 上海至纽约海运价格涨近150%

中国高锰酸钾行业发展现状及未来发展前景深度分析:高锰酸钾发展前景受到多个因素的影响